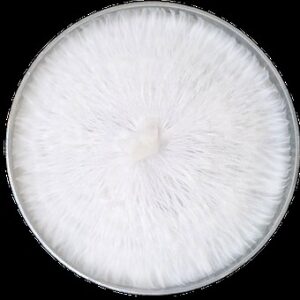
Fully Colonized Agar Plate

Showing 1–9 of 28 results
-

Mushroom Madness Grow Kit
$224.00$224.00 -

Blue Magnolia Liquid Culture Syringe
$20.00$20.00 -

Get Faded Snapback Trucker Hat
$25.00$25.00 -

Get Faded Limited Edition Purple Tee
$25.00$25.00Select options This product has multiple variants. The options may be chosen on the product page -

Long Sleeve Tee
$40.00$40.00Select options This product has multiple variants. The options may be chosen on the product page -

Crazy Comfy Hoodie
$45.00$45.00Select options This product has multiple variants. The options may be chosen on the product page -
SOLD OUT
Fully Colonized Agar Plate
$0.00 -

Get Faded Classic Tee
$25.00$25.00Select options This product has multiple variants. The options may be chosen on the product page -

Get Faded Sticker
$3.00$3.00
